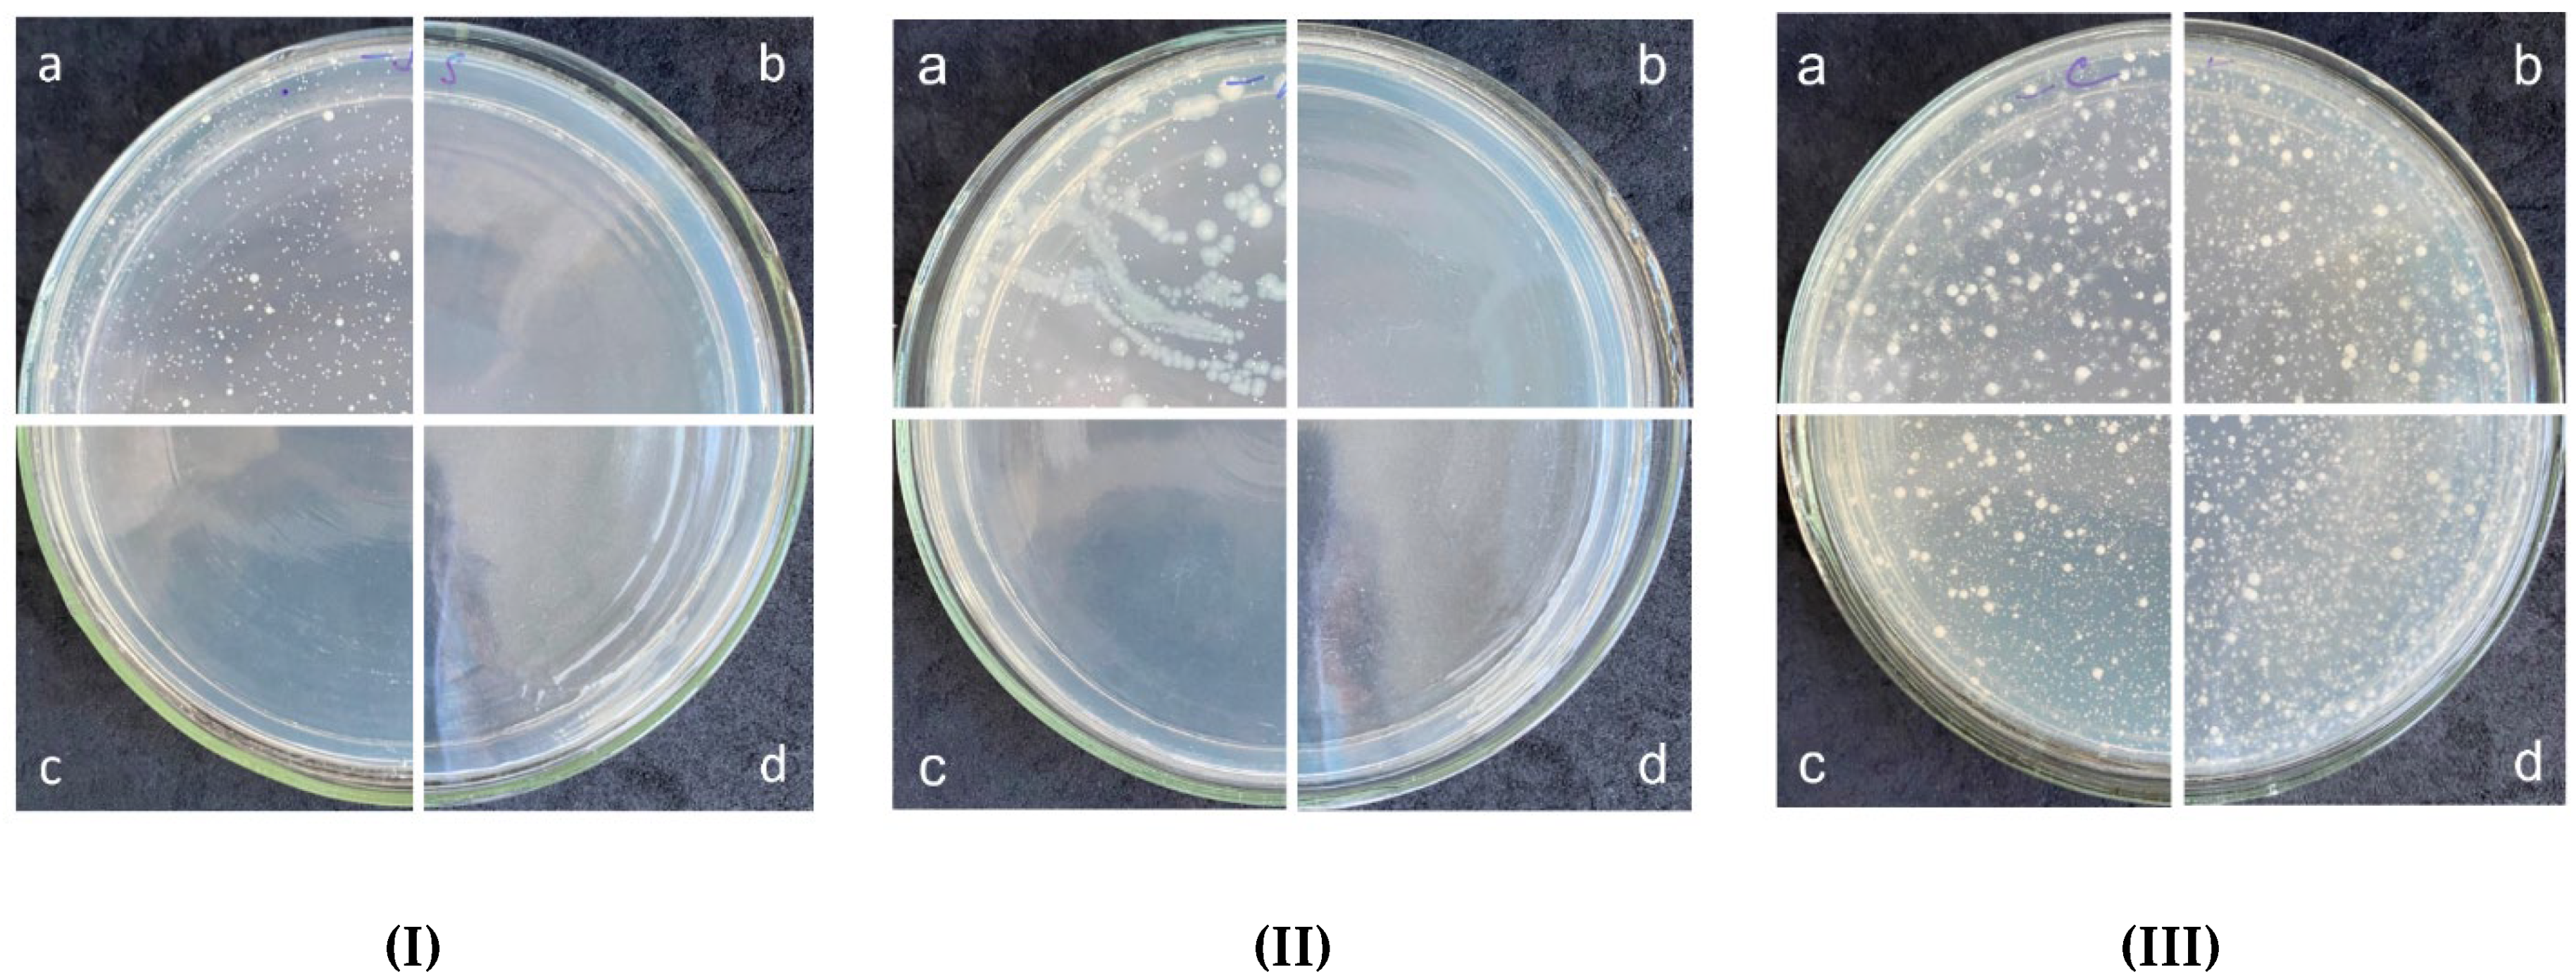

Antimicrobial Properties of the Triclosan-Loaded Polymeric Composite Based on Unsaturated Polyester Resin: Synthesis, Characterization and Activity
Abstract
1. Introduction
2. Materials and Methods
2.1. Materials
2.2. Synthesis of Polymer Composites with Triclosan
2.3. Characterization of Polymer Composite
2.4. Antimicrobial Activity Tests of Polymer Composite
2.4.1. Preparation of Test Samples
2.4.2. Preparation of Suspensions of Test Strains
2.4.3. Inoculation
2.4.4. Washing Samples with a Neutralizing Agent
2.4.5. Inoculation and Counting Colony Forming Units (CFU)
2.4.6. Number Determination of the Viable Bacteria
3. Results and Discussion
3.1. Synthesis of Polymer Composite with Triclosan
3.2. Antimicrobial Activity of Polymer Composite with Triclosan
4. Conclusions
Supplementary Materials
Author Contributions
Funding
Institutional Review Board Statement
Informed Consent Statement
Data Availability Statement
Acknowledgments
Conflicts of Interest
References
- Lode, H.M. Clinical impact of antibiotic-resistant Gram-positive pathogens. Clin. Microbiol. Infect. 2009, 15, 212–217. [Google Scholar] [CrossRef] [PubMed]
- Bhattacharjee, T.; Datta, S.S. Bacterial hopping and trapping in porous media. Nat. Commun. 2019, 10, 2–10. [Google Scholar] [CrossRef] [PubMed]
- Zhong, H.; Liu, G.; Jiang, Y.; Yang, J.; Liu, Y.; Yang, X.; Liu, Z.; Zeng, G. Transport of bacteria in porous media and its enhancement by surfactants for bioaugmentation: A review. Biotechnol. Adv. 2017, 35, 490–504. [Google Scholar] [CrossRef]
- Munir, M.T.; Pailhoriès, H.; Aviat, F.; Lepelletier, D.; Pape, P.L.; Dubreil, L.; Irle, M.; Buchner, J.; Eveillard, M.; Federighi, M.; et al. Hygienic perspectives of wood in healthcare buildings. Hygiene 2021, 1, 12–23. [Google Scholar] [CrossRef]
- Siedenbiedel, F.; Tiller, J.C. Antimicrobial polymers in solution and on surfaces: Overview and functional principles. Polymers 2012, 4, 46–71. [Google Scholar] [CrossRef]
- Kenawy, E.R.; Worley, S.D.; Broughton, R. The chemistry and applications of antimicrobial polymers: A state-of-the-art review. Biomacromolecules 2007, 8, 1359–1384. [Google Scholar] [CrossRef]
- Muñoz-Bonilla, A.; Fernández-García, M. Polymeric materials with antimicrobial activity. Prog. Polym. Sci. 2012, 37, 281–339. [Google Scholar] [CrossRef]
- Divya, K.; Vijayan, S.; George, T.K.; Jisha, M.S. Antimicrobial properties of chitosan nanoparticles: Mode of action and factors affecting activity. Fibers Polym. 2017, 18, 221–230. [Google Scholar] [CrossRef]
- Chen, J.; Dong, Y.; Xiao, C.; Tao, Y.; Wang, X. Organocatalyzed ring-opening polymerization of cyclic lysine derivative: Sustainable access to cationic poly(ϵ-lysine) Mimics. Macromolecules 2021, 54, 2226–2231. [Google Scholar] [CrossRef]
- Charnley, M.; Textor, M.; Acikgoz, C. Designed polymer structures with antifouling–antimicrobial properties. React. Funct. Polym. 2011, 71, 329–334. [Google Scholar] [CrossRef]
- Noimark, S.; Weiner, J.; Noor, N.; Allan, E.; Williams, C.K.; Shaffer, M.S.P.; Parkin, I.P. Dual-mechanism antimicrobial polymer-ZnO nanoparticle and crystal violet-encapsulated silicone. Adv. Funct. Mater. 2015, 25, 1367–1373. [Google Scholar] [CrossRef]
- Li, X.; Liu, Y.; Jiang, Z.; Li, R.; Ren, X.; Huang, T.S. Synthesis of an N-halamine monomer and its application in antimicrobial cellulose via an electron beam irradiation process. Cellulose 2015, 22, 3609–3617. [Google Scholar] [CrossRef]
- Álvarez-Paino, M.; Muñoz-Bonilla, A.; Fernández-García, M. Antimicrobial polymers in the nano-world. Nanomaterials 2017, 7, 48. [Google Scholar] [CrossRef] [PubMed]
- Vilas, J.L.; Laza, J.M.; Garay, M.T.; Rodríguez, M.; León, L.M. Unsaturated polyester resins cure: Kinetic, rheologic, and mechanical-dynamical analysis. I. Cure kinetics by DSC and TSR. J. Appl. Polym. Sci. 2001, 79, 447–457. [Google Scholar] [CrossRef]
- Ribeiro, F.V.; Casati, M.Z.; Casarin, R.C.; Corrêa, M.G.; Cirano, F.R.; Negri, B.M.; Pimentel, S.P. Impact of a triclosan-containing toothpaste during the progression of experimental peri-implant mucositis: Clinical parameters and local pattern of osteo-immunoinflammatory mediators in peri-implant fluid. J. Periodontol. 2018, 89, 203–212. [Google Scholar] [CrossRef]
- Halla, N.; Fernandes, I.P.; Heleno, S.A.; Costa, P.; Boucherit-Otmani, Z.; Boucherit, K.; Rodrigues, A.E.; Ferreira, I.C.F.R.; Barreiro, M.F. Cosmetics preservation: A review on present strategies. Molecules 2018, 23, 1571. [Google Scholar] [CrossRef]
- Fisher, L.E.; Hook, A.L.; Ashraf, W.; Yousef, A.; Barrett, D.A.; Scurr, D.J.; Chen, X.; Smith, E.F.; Fay, M.; Parmenter, C.D.J.; et al. Biomaterial modification of urinary catheters with antimicrobials to give long-term broadspectrum antibiofilm activity. J. Control. Release 2015, 202, 57–64. [Google Scholar] [CrossRef]
- Kampf, G.; Kramer, A. Epidemiologic background of hand hygiene and evaluation of the most important agents for scrubs and rubs. Clin. Microbiol. Rev. 2004, 17, 863–893. [Google Scholar] [CrossRef]
- Wegehaupt, F.J.; Tauböck, T.T.; Attin, T.; Belibasakis, G.N. Influence of light-curing mode on the cytotoxicity of resin-based surface sealants. BMC Oral Health 2014, 14, 48. [Google Scholar] [CrossRef][Green Version]
- Cunha, D.A.; Rodrigues, N.S.; Souza, L.C.; Lomonaco, D.; Rodrigues, F.P.; Degrazia, F.W.; Collares, F.M.; Sauro, S.; de Paulo Aragão Saboia, V. Physicochemical and microbiological assessment of an experimental composite doped with Triclosan-loaded halloysite nanotubes. Materials 2018, 11, 1080. [Google Scholar] [CrossRef]
- Degrazia, F.W.; Genari, B.; Leitune, V.C.B.; Arthur, R.A.; Luxan, S.A.; Samuel, S.M.W.; Collares, F.M.; Sauro, S. Polymerisation, antibacterial and bioactivity properties of experimental orthodontic adhesives containing triclosan-loaded halloysite nanotubes. J. Dent. 2018, 69, 77–82. [Google Scholar] [CrossRef] [PubMed]
- Genari, B.; Leitune, V.C.B.; Jornada, D.S.; Camassola, M.; Arthur, R.A.; Pohlmann, A.R.; Guterres, S.S.; Collares, F.M.; Samuel, S.M.W. Antimicrobial effect and physicochemical properties of an adhesive system containing nanocapsules. Dent. Mater. 2017, 33, 735–742. [Google Scholar] [CrossRef] [PubMed]
- Machado, A.H.S.; Garcia, I.M.; Motta, A.d.S.d.; Leitune, V.C.B.; Collares, F.M. Triclosan-loaded chitosan as antibacterial agent for adhesive resin. J. Dent. 2019, 83, 33–39. [Google Scholar] [CrossRef] [PubMed]
- Kamalipour, J.; Masoomi, M.; Khonakdar, H.A.; Razavi, S.M.R. Preparation and release study of Triclosan in polyethylene/Triclosan anti-bacterial blend. Colloids Surf. B Biointerfaces 2016, 145, 891–898. [Google Scholar] [CrossRef] [PubMed]
- Kaffashi, B.; Davoodi, S.; Oliaei, E. Poly(ϵ-caprolactone)/triclosan loaded polylactic acid nanoparticles composite: A long-term antibacterial bionanocomposite with sustained release. Int. J. Pharm. 2016, 508, 10–21. [Google Scholar] [CrossRef]
- Palza, H.; Quijada, R.; Delgado, K. Antimicrobial polymer composites with copper micro- and nanoparticles: Effect of particle size and polymer matrix. J. Bioact. Compat. Polym. 2015, 30, 366–380. [Google Scholar] [CrossRef]
- Yılmaz Atay, H.; Çelik, E. Investigations of antibacterial activity of chitosan in the polymeric composite coatings. Prog. Org. Coat. 2017, 102, 194–200. [Google Scholar] [CrossRef]
- Shafiq, M.; Yasin, T.; Shaista, R.A.M. Structural, thermal, and antibacterial properties of chitosan/ZnO composites. Polym. Polym. Compos. 2013, 16, 101–113. [Google Scholar] [CrossRef]
- Yudovin-Farber, I.; Beyth, N.; Weiss, E.I.; Domb, A.J. Antibacterial effect of composite resins containing quaternary ammonium polyethyleneimine nanoparticles. J. Nanopart. Res. 2010, 12, 591–603. [Google Scholar] [CrossRef]
- Ferfera-Harrar, H.; Aiouaz, N.; Dairi, N.; Hadj-Hamou, A.S. Preparation of chitosan-g-poly(acrylamide)/montmorillonite superabsorbent polymer composites: Studies on swelling, thermal, and antibacterial properties. J. Appl. Polym. Sci. 2014, 131, 39747. [Google Scholar] [CrossRef]
- Zapata, P.A.; Larrea, M.; Tamayo, L.; Rabagliati, F.M.; Azócar, M.I.; Páez, M. Polyethylene/silver-nanofiber composites: A material for antibacterial films. Mater. Sci. Eng. C 2016, 69, 1282–1289. [Google Scholar] [CrossRef] [PubMed]
- Weng, Y.; Howard, L.; Guo, X.; Chong, V.J.; Gregory, R.L.; Xie, D. A novel antibacterial resin composite for improved dental restoratives. J. Mater. Sci. Mater. Med. 2012, 23, 1553–1561. [Google Scholar] [CrossRef] [PubMed]
- Rogalsky, S.; Bardeau, J.F.; Wu, H.; Lyoshina, L.; Bulko, O.; Tarasyuk, O.; Makhno, S.; Cherniavska, T.; Kyselov, Y.; Koo, J.H. Structural, thermal and antibacterial properties of polyamide 11/polymeric biocide polyhexamethylene guanidine dodecylbenzenesulfonate composites. J. Mater. Sci. 2016, 51, 7716–7730. [Google Scholar] [CrossRef]
- Woo, G.L.Y.; Mittelman, M.W.; Santerre, J.P. Synthesis and characterization of a novel biodegradable antimicrobial polymer. Biomaterials 2000, 21, 1235–1246. [Google Scholar] [CrossRef]
- Zhao, J.; Ma, L.; Millians, W.; Wu, T.; Ming, W. Dual-functional antifogging/antimicrobial polymer coating. ACS Appl. Mater. Interfaces 2016, 8, 8737–8742. [Google Scholar] [CrossRef] [PubMed]
- Jiang, J.; Zhu, L.; Zhu, L.; Zhang, H.; Zhu, B.; Xu, Y. Antifouling and antimicrobial polymer membranes based on bioinspired polydopamine and strong hydrogen-bonded poly(n-vinyl pyrrolidone). ACS Appl. Mater. Interfaces 2013, 5, 12895–12904. [Google Scholar] [CrossRef]
- Namivandi-Zangeneh, R.; Sadrearhami, Z.; Bagheri, A.; Sauvage-Nguyen, M.; Ho, K.K.K.; Kumar, N.; Wong, E.H.H.; Boyer, C. Nitric oxide-loaded antimicrobial polymer for the synergistic eradication of bacterial biofilm. ACS Macro Lett. 2018, 7, 592–597. [Google Scholar] [CrossRef]
- Piotto, S.; Concilio, S.; Sessa, L.; Iannelli, P.; Porta, A.; Calabrese, E.C.; Galdi, M.R.; Incarnato, L. Novel antimicrobial polymer films active against bacteria and fungi. Polym. Compos. 2013, 34, 1489–1492. [Google Scholar] [CrossRef]
- Zakiruly, O. Polymer composite for production of multifunctional material. Kazakhstan Pat. 2019, 33515, 1–3. [Google Scholar]
- Djouonkep, L.D.W.; Tamo, A.K.; Doench, I.; Selabi, N.B.S.; Ilunga, E.M.; Lenwoue, A.R.K.; Gauthier, M.; Cheng, Z.; Osorio-Madrazo, A. Synthesis of high performance thiophene–aromatic polyesters from bio-sourced organic acids and polysaccharide-derived diol: Characterization and degradability studies. Molecules 2022, 27, 325. [Google Scholar] [CrossRef]
- Wiegand, C.; Völpel, A.; Ewald, A.; Remesch, M.; Kuever, J.; Bauer, J.; Griesheim, S.; Hauser, C.; Thielmann, J.; Tonndorf-Martini, S.; et al. Critical physiological factors influencing the outcome of antimicrobial testing according to ISO 22196/JIS Z 2801. PLoS ONE 2018, 13, e0194339. [Google Scholar] [CrossRef] [PubMed]
- Bojar, W.; Kazmierska, K.; Szalwinski, M.; Zareba, T. Triclosan-coated sutures in oral surgery. Adv. Clin. Exp. Med. 2009, 18, 401–405. [Google Scholar]
- Jones, G.L.; Muller, C.T.; O’Reilly, M.; Stickler, D.J. Effect of triclosan on the development of bacterial biofilms by urinary tract pathogens on urinary catheters. J. Antimicrob. Chemother. 2006, 57, 266–272. [Google Scholar] [CrossRef] [PubMed]
- Zu, G.; Steinmüller, M.; Keskin, D.; Van Der Mei, H.C.; Mergel, O.; Van Rijn, P. Antimicrobial nanogels with nanoinjection capabilities for delivery of the hydrophobic antibacterial agent Triclosan. ACS Appl. Polym. Mater. 2020, 2, 5779–5789. [Google Scholar] [CrossRef] [PubMed]
- Maiden, M.M.; Hunt, A.M.A.; Zachos, M.P.; Gibson, J.A.; Hurwitz, M.E.; Mulks, M.H.; Waters, C.M. Triclosan is an aminoglycoside adjuvant for eradication of Pseudomonas aeruginosa biofilms. Antimicrob. Agents Chemother. 2018, 62, e00146-18. [Google Scholar] [CrossRef]
- Raut, J.; Chauhan, N.; Shinde, R.; Karuppayil, S.M. Inhibition of planktonic and biofilm growth of Candida albicans reveals novel antifungal activity of caffeine. J. Med. Plant. Res. 2013, 7, 777. [Google Scholar] [CrossRef]

| Title | Support Matrix | Antimicrobial Agent | Antimicrobial Activity Target | Ref. |
|---|---|---|---|---|
| Triclosan-loaded chitosan as antibacterial agent for adhesive resin | Chitosan | Triclosan | Streptococcus mutans | [23] |
| Preparation and release study of Triclosan in polyethylene/Triclosan anti-bacterial blend | Polyethylene | Triclosan | Escherichia coli; Klebsiella pneumoniae; Staphylococcus aureus | [24] |
| Poly(ε-caprolactone)/Triclosan loaded polylactic acid nanoparticles composite: a longterm antibacterial bionanocomposite with sustained release | Poly(ε-caprolactone)/polylactic acid nanoparticles | Triclosan | Staphylococcus aureus; Escherichia coli | [25] |
| Antimicrobial polymer composites with copper micro- and nanoparticles: effect of particle size and polymer matrix | Polypropylene; polyamide 6; high-density polyethylene | Copper NPs | Staphylococcus aureus; Pseudomonas aeruginosa | [26] |
| Investigations of antibacterial activity of chitosan in the polymeric composite coatings | Chitosan | Acrylic resin | Staphylococcus aureus, | [27] |
| Structural, thermal, and antibacterial properties of chitosan/ZnO composites | Chitosan | Zinc oxide | Pseudomonas aeruginosa; Escherichia coli; Staphylococcus aureus | [28] |
| Antibacterial effect of composite resins containing quaternary ammonium polyethyleneimine nanoparticles | Restorative composite resin | Quaternary ammonium polyethyleneimine | Streptococcus mutans | [29] |
| Preparation of chitosan-g-poly(acrylamide)/montmorillonite superabsorbent polymer composites: studies on swelling, thermal, and antibacterial properties | Chitosan-g- poly(acrylamide)/montmorillonite | Chitosan | Staphylococcus aureus; Escherichia coli | [30] |
| Polyethylene/silver-nanofiber composites: a material for antibacterial films | Polyethylene | Silver nanofiber | Escherichia coli | [31] |
| A novel antibacterial resin composite for improved dental restoratives | Composite resin | Functional furanone derivative | Streptococcus mutans | [32] |
| Structural, thermal and antibacterial properties of polyamide 11/polymeric biocide polyhexamethylene guanidine dodecylbenzenesulfonate composites | Polyamide 11/polymeric biocide polyhexamethylene guanidine | Dodecylbenzenesulfonate | Escherichia coli; Bacillus subtilis | [33] |
| Synthesis and characterization of a novel biodegradable antimicrobial polymer | Polyurethane (1,6-hexane diisocyanate, polycaprolactone diol) | Ciprofloxacin (fluoroquinolone antibiotic) | Pseudomonas aeruginosa | [34] |
| Dual-functional antifogging/antimicrobial polymer coating | Poly(2-(dimethylamino)- ethyl methacrylate-co-methyl methacrylate) and polymerized ethylene glycol dimethacrylate network | Quaternary ammonium compound | Staphylococcus epidermidis; Escherichia coli | [35] |
| Antifouling and antimicrobial polymer membranes based on bioinspired polydopamine and strong hydrogen-bonded poly(N-vinyl pyrrolidone) | Polypropylene coated with a polydopamine layer and modified by poly(N-vinyl pyrrolidone) | Iodine | Staphylococcus aureus | [36] |
| Nitric oxide-loaded antimicrobial polymer for the synergistic eradication of bacterial biofilm | Polymer of oligoethylene glycol, hydrophobic ethylhexyl and cationic primary amine | Nitric oxide | Pseudomonas aeruginosa | [37] |
| Dual-mechanism antimicrobial polymer–ZnO nanoparticle and crystal violet-encapsulated silicone | Medical grade silicone | Di(octyl)- phosphinic acid capped ZnO nanoparticles | Staphylococcus aureus; Escherichia coli | [11] |
| Novel antimicrobial polymer films active against bacteria and fungi | Polypropylene and linear low-density polyethylene | 4′-hydroxy-(4- hydroxy-3-ethyl)-azobenzene (azo-dye) | Staphilococcus aureus; Candida albicans | [38] |
| Sample Name | Composition of Samples | Weight % |
|---|---|---|
| Reference polymer composite | Unsaturated polyester resin | 28 |
| Calcium carbonate | 70 | |
| Methyl ethyl ketone peroxide (MEKP) | 2 | |
| Triclosan loaded polymer composite | Unsaturated polyester resin | 28 |
| Calcium carbonate | 65 | |
| Methyl ethyl ketone peroxide (MEKP) | 2 | |
| Triclosan | 5 |
| Surface Type of Sample | Chemical Composition | ||||
|---|---|---|---|---|---|
| Sample | calcium carbonate, unsaturated ester of orthophthalic acid, methyl ethyl ketone peroxide, triclosan content 5 wt.%; 8 cm in diameter | ||||
| Reference sample | calcium carbonate, unsaturated ester of orthophthalic acid, methyl ethyl ketone peroxide without triclosan; 8 cm in diameter | ||||
| Release liner size | 40 mm × 40 mm | ||||
| Test strains cultivation Medium | Nutrient agar, pH 7.4 ± 0.2 | Incubation time and conditions | 37 ± 1 °C; 18–24 h | ||
| Inoculum preparation medium | 1/250 Nutrient broth, pH 7.4 ± 0.2 | Inoculum concentration | 2.5–10.0 × 105 CFU/mL | Amount of applied inoculum | 0.4 mL |
| Contact time and incubation conditions | 37 ± 1 °C; Humidity: ≥90%, 2 h | ||||
| Neutralizer | Tryptic soy broth with lecithin and tween-80, pH 6.8–7.2 | ||||
| Medium for counting CFU | Nutrient agar, pH 7.4 ± 0.2 | Incubation time and conditions | 37 ± 1 °C; 40–48 h | ||
| Chemical Elements | Content in Polymer Composite | Polymer Composite with 5 wt.%-Triclosan |
|---|---|---|
| Mg | 0.40 | 0.39 |
| Ca | 48.99 | 47.61 |
| S | 0.02 | 0.02 |
| Fe | 0.01 | 0.01 |
| Cl | - | 1.67 |
| Sample | Ca | Mg | C | O | Cl |
|---|---|---|---|---|---|
| Polymer composite | 21.87 | 0.56 | 32.00 | 45.57 | - |
| Polymer composite with 5 wt.%-triclosan | 22.89 | 0.77 | 29.97 | 44.45 | 1.92 |
| Sample | C | H | N | S |
|---|---|---|---|---|
| Polymer composite | 25.95 ± 0.34 | 1.14 ± 0.15 | 4.99 ± 0.71 | 0.32 ± 0.05 |
| Polymer composite with 5 wt.%-triclosan | 24.49 ± 0.52 | 1.24 ± 0.02 | 2.36 ± 0.45 | 0.28 ± 0.01 |
| Strain | Contact Time | Sample | Average CFU | Average log10 | Antimicrobial Activity, log10 | Antimicrobial Activity,% |
|---|---|---|---|---|---|---|
| S. aureus 6538-P | 5 min | negative control | 7.50 × 103 | 3.875 | 5.079 | 100 |
| composite triclosan | 0.06 | −1.204 | ||||
| S. aureus 39 | 5 min | negative control | 6.38 × 103 | 3.804 | 5.009 | 100 |
| composite triclosan | 0.06 | −1.204 | ||||
| S. epidermidis 12228 | 5 min | negative control | 4.16 × 103 | 3.619 | 4.823 | 100 |
| composite triclosan | 0.06 | −1.204 | ||||
| Kl. pneumoniae 10031 | 5 min | negative control | 2.91 × 103 | 3.463 | 4.667 | 100 |
| composite triclosan | 0.06 | −1.204 | ||||
| Kl. pneumoniae 700603 | 5 min | negative control | 8.88 × 103 | 3.948 | 0.005 | 1.1 |
| composite triclosan | 8.78 × 103 | 3.944 | ||||
| 15 min | negative control | 9.06 × 103 | 3.957 | 0.006 | 1.4 | |
| composite triclosan | 8.94 × 103 | 3.951 | ||||
| 30 min | negative control | 7.19 × 103 | 3.857 | 0.006 | 1.3 | |
| composite triclosan | 7.09 × 103 | 3.851 | ||||
| 1 h | negative control | 7.16 × 103 | 3.855 | 0.006 | 1.3 | |
| composite triclosan | 7.06 × 103 | 3.849 | ||||
| 2 h | negative control | 6.19 × 103 | 3.792 | 0.104 | 21.2 | |
| composite triclosan | 4.88 × 103 | 3.688 | ||||
| 4 h | negative control | 2.05 × 104 | 4.311 | 1.135 | 92.7 | |
| composite triclosan | 1.50 × 103 | 3.176 | ||||
| Ps. aeruginosa 9027 | 5 min | negative control | 8.34 × 103 | 3.921 | 0.002 | 0.4 |
| composite triclosan | 8.31 × 103 | 3.920 | ||||
| 15 min | negative control | 6.66 × 103 | 3.823 | 0.002 | 0.5 | |
| composite triclosan | 6.73 × 103 | 3.821 | ||||
| 30 min | negative control | 6.94 × 103 | 3.841 | 0.004 | 0.9 | |
| composite triclosan | 6.88 × 103 | 3.837 | ||||
| 1 h | negative control | 6.69 × 103 | 8.825 | 0.004 | 0.9 | |
| composite triclosan | 6.63 × 103 | 3.821 | ||||
| 2 h | negative control | 5.72 × 103 | 3.757 | 0.005 | 1.1 | |
| composite triclosan | 5.66 × 103 | 3.753 | ||||
| 4 h | negative control | 3.31 × 103 | 3.520 | 0.849 | 85.8 | |
| composite triclosan | 0.47 × 103 | 2.671 | ||||
| Ps. aeruginosa TA2 | 5 min | negative control | 2.66 × 103 | 3.424 | 0.016 | 3.5 |
| composite triclosan | 2.56 × 103 | 3.409 | ||||
| 15 min | negative control | 2.84 × 103 | 3.454 | 0.020 | 4.4 | |
| composite triclosan | 2.72 × 103 | 3.434 | ||||
| 30 min | negative control | 3.00 × 103 | 3.477 | 0.018 | 4.2 | |
| composite triclosan | 2.88 × 103 | 3.459 | ||||
| 1 h | negative control | 1.66 × 103 | 3.219 | 0.034 | 7.5 | |
| composite triclosan | 1.53 × 103 | 3.185 | ||||
| 2 h | negative control | 1.22 × 103 | 3.086 | 0.086 | 17.9 | |
| composite triclosan | 1.00 × 103 | 3.00 | ||||
| 4 h | Negative control | 1.19 × 103 | 3.075 | 0.088 | 18.4 | |
| Composite triclosan | 0.97 × 103 | 2.986 | ||||
| C. albicans 10231 | 5 min | Negative control | 1.12 × 104 | 4.049 | 0.001 | 0.3 |
| Composite triclosan | 1.12 × 104 | 4.048 | ||||
| 15 min | Negative control | 1.08 × 104 | 4.034 | 0.001 | 0.3 | |
| Composite triclosan | 1.08 × 104 | 4.033 | ||||
| 30 min | Negative control | 9.16 × 103 | 3.962 | 0.001 | 0.3 | |
| Composite triclosan | 9.13 × 103 | 3.960 | ||||
| 1 h | Negative control | 3.38 × 103 | 3.972 | 0.004 | 1.0 | |
| Composite triclosan | 3.97 × 103 | 3.968 | ||||
| 2 h | Negative control | 1.08 × 104 | 4.035 | 0.006 | 1.4 | |
| Composite triclosan | 1.07 × 104 | 4.029 | ||||
| 4 h | Negative control | 9.97 × 103 | 3.999 | 0.007 | 1.6 | |
| Composite triclosan | 9.81 × 103 | 3.992 | ||||
| C. albicans 2091 | 5 min | Negative control | 8.19 × 103 | 3.913 | 0.002 | 0.4 |
| Composite triclosan | 8.16 × 103 | 3.911 | ||||
| 15 min | Negative control | 5.28 × 103 | 3.723 | 0.003 | 0.6 | |
| Composite triclosan | 5.25 × 103 | 3.720 | ||||
| 30 min | Negative control | 5.53 × 103 | 3.743 | 0.002 | 0.6 | |
| Composite triclosan | 5.50 × 103 | 3.740 | ||||
| 1 h | Negative control | 5.12 × 103 | 3.710 | 0.003 | 0.6 | |
| Composite triclosan | 5.09 × 103 | 3.707 | ||||
| 2 h | Negative control | 5.09 × 103 | 3.707 | 0.051 | 11.0 | |
| Composite triclosan | 4.53 × 103 | 3.656 | ||||
| 4 h | Negative control | 3.84 × 103 | 3.585 | 0.747 | 82.1 | |
| Composite triclosan | 0.69 × 103 | 2.837 | ||||
| C. albicans (clinical isolate) | 5 min | Negative control | 8.38 × 103 | 3.923 | 0.002 | 0.4 |
| Composite triclosan | 8.34 × 103 | 3.921 | ||||
| 15 min | Negative control | 8.78 × 103 | 3.944 | 0.002 | 0.4 | |
| Composite triclosan | 8.75 × 103 | 3.942 | ||||
| 30 min | Negative control | 8.63 × 103 | 3.936 | 0.003 | 0.7 | |
| Composite triclosan | 8.56 × 103 | 3.933 | ||||
| 1 h | Negative control | 8.97 × 103 | 3.953 | 0.181 | 34.1 | |
| Composite triclosan | 5.91 × 103 | 3.771 | ||||
| 2 h | Negative control | 1.67 × 104 | 4.222 | 0.352 | 55.5 | |
| Composite triclosan | 7.41 × 103 | 3.870 | ||||
| 4 h | Negative control | 8.84 × 103 | 3.947 | 1.109 | 92.2 | |
| Composite triclosan | 0.69 × 103 | 2.837 |
Publisher’s Note: MDPI stays neutral with regard to jurisdictional claims in published maps and institutional affiliations. |
© 2022 by the authors. Licensee MDPI, Basel, Switzerland. This article is an open access article distributed under the terms and conditions of the Creative Commons Attribution (CC BY) license (https://creativecommons.org/licenses/by/4.0/).
Share and Cite
Tauanov, Z.; Zakiruly, O.; Baimenova, Z.; Baimenov, A.; Akimbekov, N.S.; Berillo, D. Antimicrobial Properties of the Triclosan-Loaded Polymeric Composite Based on Unsaturated Polyester Resin: Synthesis, Characterization and Activity. Polymers 2022, 14, 676. https://doi.org/10.3390/polym14040676
Tauanov Z, Zakiruly O, Baimenova Z, Baimenov A, Akimbekov NS, Berillo D. Antimicrobial Properties of the Triclosan-Loaded Polymeric Composite Based on Unsaturated Polyester Resin: Synthesis, Characterization and Activity. Polymers. 2022; 14(4):676. https://doi.org/10.3390/polym14040676
Chicago/Turabian StyleTauanov, Zhandos, Olzhas Zakiruly, Zhuldyz Baimenova, Alzhan Baimenov, Nuraly S. Akimbekov, and Dmitriy Berillo. 2022. "Antimicrobial Properties of the Triclosan-Loaded Polymeric Composite Based on Unsaturated Polyester Resin: Synthesis, Characterization and Activity" Polymers 14, no. 4: 676. https://doi.org/10.3390/polym14040676
APA StyleTauanov, Z., Zakiruly, O., Baimenova, Z., Baimenov, A., Akimbekov, N. S., & Berillo, D. (2022). Antimicrobial Properties of the Triclosan-Loaded Polymeric Composite Based on Unsaturated Polyester Resin: Synthesis, Characterization and Activity. Polymers, 14(4), 676. https://doi.org/10.3390/polym14040676








